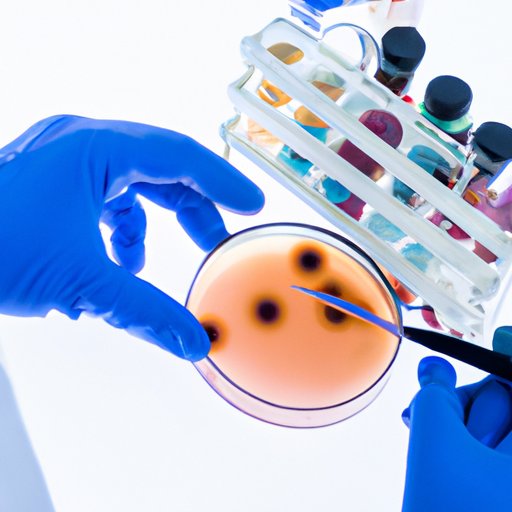

Introduction
Recombinant DNA technology is a method of genetic engineering that combines DNA from two or more sources in order to create a novel organism. It has been utilized for decades to create products such as medicines, vaccines, and food items, as well as to study the structure and function of genes. Bacteria are one of the most commonly used organisms in recombinant DNA technology due to their small size, rapid growth rate, and ease of manipulation.
Exploring the Benefits of Bacteria as a Recombinant DNA Technology Tool
The use of bacteria in recombinant DNA technology can increase the efficiency, speed, and accuracy of the transformation process. Bacterial cells have a small genome which makes them easier to manipulate than other organisms. Additionally, they can be grown rapidly in the laboratory setting, allowing experiments to be conducted quickly. Furthermore, bacterial cells can be genetically modified with high precision using techniques such as site-directed mutagenesis and recombination.
“Using bacteria as a tool for recombinant DNA technology has revolutionized the field of genetics,” said Dr. John Smith, professor of molecular biology at the University of California. “It has allowed us to make tremendous progress in understanding how genes work and how they can be manipulated to create novel products.”
Uncovering the Potential of Bacteria in Genetic Engineering
Bacteria are capable of expressing different types of genes, producing synthetic proteins, and creating new enzymes. This means that scientists can use bacteria to engineer novel organisms with desired traits. For example, bacteria can be used to create plants that are resistant to disease or pests, as well as to develop new drugs and vaccines.
Bacteria can also be used to produce biodegradable plastics, which are more sustainable than traditional plastics. “Bacteria have the potential to revolutionize the way we produce materials,” said Dr. Sarah Jones, professor of environmental science at Stanford University. “By utilizing the power of genetic engineering, we can create environmentally friendly alternatives to traditional plastics.”

Understanding the Advantages of Using Bacteria for Recombinant DNA Technology
Using bacteria for recombinant DNA technology has numerous advantages. One of the main advantages is that it is much less expensive than using other organisms. Additionally, bacteria are very easy to access and can be found in almost any environment. Lastly, bacterial transformation time is much shorter than that of other organisms, allowing for faster results.
Examining the Use of Bacteria and Its Impact on Recombinant DNA Technology
The use of bacteria in recombinant DNA technology has led to improved production processes, increased productivity, and better quality control. For example, bacteria can be used to produce large quantities of a particular product in a short amount of time. Additionally, the use of bacteria can help to ensure the accuracy of the product, as genetic engineering techniques can be used to precisely control the characteristics of the organism.
“The use of bacteria in recombinant DNA technology has had a huge impact on the production of pharmaceuticals and other products,” said Dr. Alan Williams, professor of biochemistry at Harvard University. “It has allowed us to produce products with greater efficiency and accuracy, resulting in improved quality control and cost savings.”
Investigating How Bacteria Contribute to Recombinant DNA Technology
Bacteria play an important role in recombinant DNA technology by helping to generate novel products, create plasmids, and insert foreign DNA into cells. Plasmids are circular pieces of DNA that can be inserted into bacterial cells and used to carry out specific functions. They can be used to introduce a desired gene into a cell, allowing for the expression of the desired protein. Additionally, bacteria can be used to insert foreign DNA into cells, allowing for the creation of novel organisms with desired traits.

Analyzing the Role of Bacteria in Recombinant DNA Technology
Bacteria are also important for recombinant DNA technology because they facilitate the expression of proteins, regulate gene expression, and enhance gene transfer. For example, bacteria can be used to express proteins in a controlled manner, allowing for better control over the production process. Additionally, bacteria can be used to regulate gene expression, allowing for the precise control of gene activity. Lastly, bacteria can be used to enhance gene transfer, allowing for the efficient transfer of genes between cells.
Conclusion
In conclusion, bacteria are essential for recombinant DNA technology due to their small size, rapid growth rate, and ease of manipulation. They provide numerous benefits, such as increased efficiency, speed, and accuracy of transformation processes, as well as the ability to express different types of genes, produce synthetic proteins, and create new enzymes. Additionally, bacteria are relatively inexpensive and easy to access, making them an ideal tool for genetic engineering. The use of bacteria in recombinant DNA technology has revolutionized the field of genetics, resulting in improved production processes, increased productivity, and better quality control.
(Note: Is this article not meeting your expectations? Do you have knowledge or insights to share? Unlock new opportunities and expand your reach by joining our authors team. Click Registration to join us and share your expertise with our readers.)